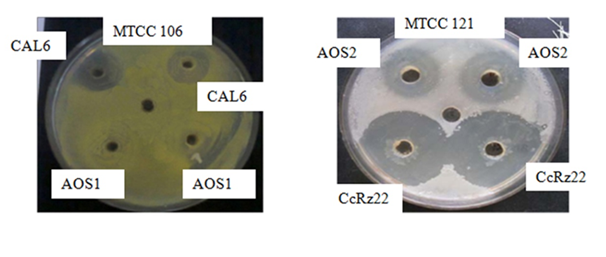
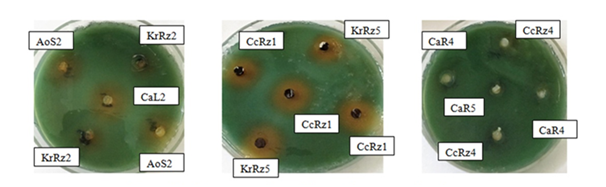

Journal of
eISSN: 2469 - 2786


Research Article Volume 4 Issue 6
Department of Biochemistry, Manipur University, India
Correspondence: Debananda S Ningthoujam, Department of Biochemistry, Microbial Biotechnology Research Laboratory(MBRL), Manipur University, Canchipur, Imphal 795 003, India
Received: January 29, 2017 | Published: May 22, 2017
Citation: Shaheen K, Mukherjee S, Ningthoujam DS. Biocontrol and PGP potential of endophytic actinobacteria from selected ethnomedicinal plants in manipur, India. J Bacteriol Mycol Open Access. 2017;4(6):181-189. DOI: 10.15406/jbmoa.2017.04.00112
The emergence of drug resistance in many bacterial pathogens and the rise of fungal infections have caused a resurgence of interest in finding new reserves of bioactive compounds. Manipur, a part of Indo-Burma hotspot, is rich in ethnomedicinal plants with folk medicinal and cultural significance. We have isolated 104 endophytic actinobacteria from 8 ethnomedicinal plants of Manipur. Eighty one (81) putative endophytic actinomycetes were selected for primary screening by cross streak method against bacterial test organisms (Micrococcus luteus, Bacillus subtilis, Escherichia coli and Pseudomonas aeruginosa). Thirty seven (37) isolates showed antibacterial activity and were further screened for other antimicrobial assays (Kirby Bauer and Dual Culture methods) against the same bacterial test organisms as well as indicator rice fungal pathogens (Curvularia oryzae, Rhizoctonia solani, Aspergillus niger, Bipolaris oryzae, Fusarium oxysporum and Pyricularia oryzae). In addition, they were subjected to various biochemical and physiological characterization tests and were also screened for plant growth promoting traits such as production of IAA, siderophore, and ammonia and solubilization of phosphate. Of 21 antagonistic isolates, 2 (CcRz4 and CaR1) were found most potent and they hold promise for further development as biocontrol agents. Optimization studies of these bioactive strains could be targets for future studies leading to biotechnological exploitation of these candidate endophytic bacteria.
Keywords: endophytic actinomycetes, antimicrobial assays, characterization tests, plant growth promoting (PGP) activities, biocontrol, manipur
Actinomycetes are unparalleled sources of bioactive natural products.1 Among microbes producing bioactive secondary metabolites, actinomycetes are the most prolific.1-5 Hence, survey of novel habitats and biotopes are warranted for discovery of novel actinomycetes and new secondary metabolites. Medicinal plants are a promising resource for isolation and screening of novel bioactive actinobacteria.
There has been a significant decline in the identification of new compounds due to re-discovery of known compounds from previously described terrestrial microbial species.6 Hence, investigation of novel and unique ecosystems for isolation of actinomycetes and for natural product-based drug discovery is crucial to overcome the problem of antibiotic resistance associated with the existing antibiotics. This trend has spurred interest in exploring the actinomycete diversity in marine environments. Not only are oceans a resource for biodiversity because of the physical properties of different ecosystems but also because many marine organisms have established endo-symbiotic and host-associated relationships with microorganisms.7,8
One biologically important but relatively overlooked niche is the inner tissues of higher plants. Endophytic actinobacteria are relatively unexplored for potential sources of novel species and novel natural products for biomedical, agricultural and industrial exploitation. The last few years has seen acceleration in research on endophytic microbes inhabiting the plants from various ecosystems.9-16
Endophytic actinobacteria have attracted attention in recent years with increasing reports of isolates from a range of plant types including crop plants and medicinal plants. They have been demonstrated to improve and promote the growth of host plants as well as to reduce disease symptoms caused by plant pathogens through various mechanisms, including production of secondary metabolites, changes in host physiology, and induction of systemic acquired resistance in plants.17 Endophytes provide a wide variety of bioactive secondary metabolites with unique structures including alkaloids, benzopyranones, chinones, flavonoids, phenolic acids, quinones, steroids, terpenoids, tetralones, xanthones, and other classes.18 Such bioactive metabolites find wide-ranging applications as agrochemicals, antibiotics, immunosuppressants, antiparasitics, antioxidants, and anticancer agents.19 Bioactive natural compounds produced by endophytes have shown greater promise over synthetic chemicals from safety and human health perspectives, although there is still a significant global demand for synthetic products due to economic and time-saving reasons.20
Continuous use of fungicides in agriculture has resulted in increased fungicide resistance, environmental pollution, detrimental effects on non-target organisms including human beings.21 In recent years, natural or biological control has received increased attraction by providing an environment friendly, long lasting, inexpensive, and safe alternative for control of plant diseases.22,23 Increased efforts have been made to screen micro-organisms for bioactive molecules antagonistic to plant pathogens. There are many reports on the use of microorganisms as biocontrol agents as an alternative to chemical fungicides.24,25 Among micro-organisms, actinomycetes of the genus Streptomyces are well known for their antagonistic potential against a wide range of fungal phytopathogens.26 Many Streptomyces spp. have been reported to produce fungal cell wall degrading enzymes such as chitinases, hemicellulases, cellulases and glucanases27 and the role of these enzymes in antifungal activity and biocontrol potential has been evaluated.29 They are also known for their ability to promote plant growth by producing plant growth hormones such as indole acetic acid, nitrogen fixation, phosphate solubilization and siderophore production.30,31
Manipur lies in the Indo-Burma hotspot in India, one of the 34 sites in the world32 that abuts the South East Asian tropical Rainforests. Though small, it has a variety of ecological zones, niche habitats and other unique biotopes. There is a great potential for discovery of bioactive actinomycete strains in Manipur for beneficial applications in medicine, agriculture and industry. There is an urgent need to explore such underexplored ecosystems of Manipur and study the distribution of actinomycetes by isolating, characterizing and screening them for discovery of novel actinomycetes and development of novel natural products with commercial biotechnological applications. In the present study, we selected some medicinal plants of Manipur for possible isolation of novel actinomycetes. The aim of the investigation was to isolate and characterize putative actinomycete and other bacterial strains, and screen their biocontrol (antagonistic) and plant growth promotion (PGP) activities.
Sampling of ethnomedicinal plants
Healthy roots, leaves, rhizomes, and stems of each plant were collected and placed in sterile bags and taken to the laboratory. The samples were subjected to isolation procedures within 96h.
8 ethnomedicinally important plants of Manipur were sampled from various parts of the state:
Isolation
Samples were washed with Tween 20, soaked in distilled water, and vortexed to remove the surface soils. After drying, the samples were subjected to a five step surface sterilization procedure.33
After thorough washing, the samples were air dried under sterile conditions. The surface treated samples were cut into small pieces (1 cm) with a sterile blade and inoculated into Starch Casein Nitrate Agar (SCNA), 2.5% Water Agar (WA), Tap Water Yeast Extract Agar (TWYE) and Tap Water Peptone Agar (TWPA). The inoculated plates were then incubated at 30˚C for 3-4 weeks. Morphologically distinct isolates were subcultured till pure cultures were obtained.
Bioactivity screening
Primary screening (Cross streak method): The endophytic isolates were cross-streaked34,35 against indicator test organisms viz. Micrococcus luteus (MTCC-106), Bacillus subtilis (MTCC-121), Escherichia coli (MTCC-739), Pseudomonas aeruginosa (DN1). The isolates were streaked in the middle of the Nutrient Agar plates and kept for 3-4 days at 30˚C. Freshly grown test organisms (MTCC-106, MTCC-121, MTCC-739, DN1) were streaked perpendicularly to the actinomycete isolate, incubated for 24-48 h and the zones of inhibition were measured. The isolates which showed inhibition of >50% against the test organisms in the primary screening were considered to be potent.
Secondary screening (Kirby Bauer method): The bioactive strains were subjected to secondary screening for antibacterial activity against the same bacterial test organisms (MTCC-106, MTCC-121, MTCC-739 and DN1) using Kirby-Bauer method.36
The strain was inoculated on Starch Casein Nitrate (SCN) Broth and kept at 30˚C on an orbital shaker (150 rpm, 7 days). The fully grown putative actinomycete cultures were centrifuged (10,000 rpm, 15 min) and the supernatants were collected in sterile falcon tubes. The test organisms were inoculated in test tubes containing Nutrient Broth (NB) and kept at 30˚C for 24 h. 100µl of freshly grown test organism was spread plated on Nutrient Agar (NA, pH 7.0) and kept for drying. Agar wells (6 mm diameter) were punched into the dried plates and filled with 0.7% soft agar up to ½ depths of the wells. The culture supernatants were then put into the wells in duplicates and kept at 4˚C for 3 h for proper diffusion. The plates were incubated at 30˚C for 4-5 days and then observed for the presence or absence of inhibition zones around the wells.
Biocontrol assays against fungal pathogens (Dual Culture Method): The bioactive strains were screened for antifungal activities against major rice fungal pathogens viz. Curvularia oryzae (MTCC 2605), Rhizoctonia solani (MTCC 4633), Aspergillus niger (MTCC 1344), Bipolaris oryzae (LSMU1), Fusarium oxysporum (MTCC 287) and Pyricularia oryzae (MTCC 1477) using the Dual culture method.37
An in vitro plate technique was used to monitor the inhibitory (antagonistic) effects of the actinomycetes against the fungal pathogens. This test was done on SDA (Sabouraud Dextrose Agar) plates. Agar wells (6 mm diameter) were punched on SDA plates using sterilized cork borer and agar plugs from the freshly grown cultures were placed on the SDA wells in duplicates. The plates were incubated at 30˚C for 48 h. For each test fungus, a 6 mm diameter SDA plug covered fully with the actively growing mycelium was placed at the centre of the plate. A plate containing a fungal agar plug without the culture was kept as control. All the plates were incubated at 30˚C until the control plate showed full growth.
The percentage growth inhibition was calculated using the formula:
Inhibition = [(R-r)/R] X 100,
Where R = Radius of the fungal growth in control plate
r = Radius of the fungal growth in test plate.
Phenotypic characterization
All the bioactive isolates shortlisted after screening were subjected to various biochemical tests (starch hydrolysis, catalase, oxidase, MR, VP, citrate utilization, indole production, nitrate reduction, gelatin liquefaction and urease tests) and physiological characterization tests (effect of different salt concentrations and pH on growth) using standard procedures.38-41
In vitro tests for plant growth promoting (PGP) traits
The bioactive isolates were further screened for plant growth promoting activities such as production of IAA, siderophore and ammonia and Phosphate solubilization.
Indole acetic acid (IAA) production
IAA production was determined according to standard procedure.42 Strains were inoculated in Starch Casein Nitrate broth (SCNB) containing 2 mg/ml of L-tryptophan (trp) and incubated on an orbital shaker (150 rpm, 30˚C, 5d). The culture broths were centrifuged (10,000 rpm, 10 min) and 1 ml of the supernatant was mixed with 2ml of Salkowski reagent. Appearance of pink color indicated IAA production.
Siderophore production
Siderophore production was assayed according to standard protocol43 with some modifications. Agar plugs (6 mm diameter) containing strains were inoculated on SCNA (without iron) amended with CAS-substrate and kept incubated at 30˚C for 7 d. Orange coloured halo zones surrounding the colonies were indicative of siderophore production.
Phosphate (P) solubilization
Solubilization of tricalcium phosphate (TCP) was determined by spot inoculation of a loopful of the isolate in National Botanical Research Institute’s Phosphate Growth Medium containing bromophenol blue (NBRIP-BPB).44 The strain fully grown on SCNA was spot inoculated in NBRIP-BP medium and kept incubated at 30°C. Formation of a halo zone surrounding the colony after 4 d indicated P solubilization.
Ammonia production
Ammonia production was screened in peptone water. Strains were inoculated in 10 ml peptone water (broth) and kept in a shaker (150 rpm, 30˚C) for 4 d. 0.5 ml of Nessler’s reagent was then added in each tube. Development of brown to yellow color indicated ammonia production.38
Sampling of medicinal plants & isolation of endophytic actinomycetes
Eight ethnomedicinally important plants of Manipur were sampled from various parts of the state (Figure 1). Putative actinomycete colonies on master plates (Figure 2) were subcultured till pure cultures were obtained. A total of 104 endophytic actinomycete isolates were obtained.

Figure 1 N=57; Epidemiological distribution of the pathological fractures, traumatic fractures, and nonunion.

Figure 2 N=57; Epidemiological distribution of the pathological fractures, traumatic fractures, and nonunion.
Bioactivity Screening of endophytic isolates
81 putative endophytic actinomycetes were selected for antimicrobial assays.
Primary screening (Cross Streak method)
Of 81 putative endophytic actinomycete isolates screened, 37 showed antibacterial activity against one or more of the test organisms (Table 1) of which 9 strains (SdL4, CcRz1, CcRz3, CcRz7, CcRz9, CcRz18, CcRz22, CaL6, CaR1) were found to be potent.
Sl. No |
Actinomycete Strains |
Test Organisms |
|||
MTCC 106 |
MTCC 121 |
MTCC 739 |
DN1 |
||
1 |
SdL4 |
+++ |
++ |
- |
- |
2 |
CcRz1 |
++ |
+ |
- |
- |
3 |
CcRz3 |
- |
++ |
- |
- |
4 |
CcRz7 |
- |
++ |
- |
- |
5 |
CcRz9 |
- |
+++ |
- |
- |
6 |
CcRz18 |
- |
++ |
- |
- |
7 |
CcRz22 |
- |
+++ |
++ |
- |
8 |
CaL6 |
+++ |
+ |
- |
- |
9 |
CaR1 |
++ |
++ |
+ |
+ |
Table 1 Primary screening of bioactive endophytic actinomycete strains
Note: +++ (> 50%), ++ (< 50%), + (< 30%), - no inhibition zone
Secondary screening (Kirby Bauer method)
All 37 bioactive actinomycete strains were subjected to secondary screening for antibacterial activity against the same bacterial test organisms. Eleven (11) endophytic strains showed antimicrobial activity against one or more of the test organisms of which 4 strains (CcRz22, CaL6, CaR5, AoS2) were found to be promising. None of the isolates showed any activity against Pseudomonas aeruginosa. (Table 2 & Figure 3).
Sl. No |
Actinomycete Strains |
MTCC 106 |
MTCC 121 |
MTCC 739 |
DN1 |
Inhibition Zone (mm) |
|||||
1 |
SdL4 |
13 |
11.6 |
- |
- |
2 |
SdL5 |
- |
- |
- |
- |
3 |
CcRz1 |
14.2 |
10.4 |
- |
- |
4 |
CcRz7 |
- |
15 |
- |
- |
5 |
CcRz9 |
- |
16.7 |
- |
- |
6 |
CcRz18 |
- |
12 |
- |
- |
7 |
CcRz22 |
- |
27.3 |
11.1 |
- |
8 |
CaR1 |
15.6 |
12.1 |
15.2 |
- |
9 |
CaR4 |
13.9 |
15.9 |
16.1 |
- |
10 |
CaR5 |
19.4 |
17.6 |
18.6 |
- |
11 |
AoS2 |
13.6 |
24.2 |
- |
- |
Table 2 Profiling of antibacterial activity of bioactive actinomycete strains (Kirby Bauer method)
An inhibition zone of 17mm or above is considered potent
Figure 3 N=57; Epidemiological distribution of the pathological fractures, traumatic fractures, and nonunion.
Biocontrol assays against fungal pathogens (Dual Culture Method)
All the 37 bioactive endophytic isolates were screened for antifungal activities against indicator rice fungal pathogens. Twenty one (21) isolates were found to have antifungal activity against one or more of the test organisms , of which 2 strains (CcRz4 and CaR1) were found to be most potent (Table 3 & Figure 4).
Sl. No |
Test Isolates |
% Mycelial Growth= [(R-r)/R]x100 |
|||||
Control |
MTCC 4633 |
MTCC 287 |
MTCC 2605 |
MTCC 1344 |
LSMU1 |
MTCC 1477 |
|
0 |
0 |
0 |
0 |
0 |
0 |
||
1 |
SdL2 |
72.5 |
66 |
65.9 |
- |
- |
- |
2 |
SdL3 |
- |
- |
- |
- |
- |
64.286 ± 1.414 |
3 |
SdL5 |
62.9 |
- |
62.1 |
- |
- |
- |
4 |
CcRz3 |
- |
- |
64.4 |
- |
- |
61.904 ± 1.414 |
5 |
CcRz4 |
69.8 |
70.1 |
72.9 |
68.2 |
59.9 |
65.676 ± 2.121 |
6 |
CcRz12 |
- |
- |
- |
- |
- |
61.904 ± 4.242 |
7 |
CcRz13 |
- |
- |
- |
- |
- |
64.286 ± 4.242 |
8 |
CcRz17 |
- |
- |
- |
- |
- |
53.571 ± 3.535 |
9 |
CcRz21 |
30.2 |
- |
- |
- |
- |
55.953 ± 0.707 |
10 |
CcRz22 |
32.6 |
- |
- |
- |
- |
58.333 ± 0.707 |
11 |
PpRz1 |
- |
- |
- |
- |
- |
66.667 ± 1.414 |
12 |
PpRz2 |
- |
- |
- |
- |
- |
61.904 ± 1.414 |
13 |
PpRz4 |
- |
- |
- |
- |
- |
61.904 ± 0.000 |
14 |
CaL2 |
- |
- |
- |
- |
- |
58.333 ± 4.949 |
15 |
CaL3 |
- |
- |
- |
- |
- |
65.476 ± 0.707 |
16 |
CaL5 |
- |
- |
33.6 |
- |
- |
61.904 ± 1.414 |
17 |
CaL6 |
59.6 |
66.9 |
48.1 |
- |
- |
59.524 ± 2.828 |
18 |
CaS4 |
- |
- |
- |
76.19 |
64.04 |
- |
19 |
CaR1 |
33.4 |
75.9 |
65.9 |
64.8 |
75.9 |
57.143 ± 1.414 |
20 |
AoS2 |
- |
- |
- |
- |
- |
57.143 ± 0.000 |
21 |
VrL2 |
- |
- |
- |
- |
- |
69.048 ± 0.000 |
Table 3 Percentage growth inhibition of the fungal pathogens by the bioactive strains

Figure 4 N=57; Epidemiological distribution of the pathological fractures, traumatic fractures, and nonunion.
Phenotypic characterization
Biochemical tests: Majority of the bioactive strains were found positive in starch hydrolysis and negative in indole production tests. 21 strains showed positive results in starch hydrolysis, 11 in catalase, 12 in oxidase, 9 in MR, 6 in VP, 20 in citrate utilization, 29 in nitrate reduction, 10 in gelatin liquefaction and 11 in urease tests. Only 1 strain (CcRz24) was positive in indole production test.
Effect of salt concentration: None of the bioactive strains except CcRz6 could grow at 10% NaCl concentration. CcRz6 could grow at 0-10% NaCl concentrations. One strain (CcRz12) could grow at 0.5-10% NaCl concentrations. CaR1 grew luxuriantly at lower NaCl concentrations (0-1%) but was unable to grow at higher salt concentrations. One strain, PpRz3, grew luxuriantly at 0-2.5% NaCl concentrations but failed to grow at higher salt concentrations). The remaining strains grew luxuriantly at 0-7% NaCl concentrations.
Effect of pH on growth: All the strains grew luxuriantly at pH 7-9. 7 strains (SdL2, SdL3, CcRz3, CcRz4, CcRz18, AoS2 and KrRz5) showed no growth at pH 5 and 6, though they could grow at pH 7-9 or pH 7-10. 11 strains (CcRz8, CcRz12, CcRz13, PpRz1, PpRz2, PpRz3, PpRz4, CaL2, CaL6, CaR1 and VrL2) failed to grow at pH 5 but grew well at pH 6-10. The rest of the bioactive isolates grew at pH 5-10.
In vitro tests for plant growth promoting (PGP) traits
Twenty-eight (28) strains showed positive results for IAA production while 14 were positive for siderophore production, 20 for phosphate solubilization test and 27 strains for ammonia production (Table 4, Figures 5 & 6).
Sl. No. |
Strains |
IAA Production |
Siderophore Production |
Phosphate Solubilisation |
Ammonia Production |
1 |
CcRz1 |
+ |
+ |
+ |
+ |
2 |
CcRz3 |
+ |
+ |
- |
+ |
3 |
CcRz4 |
+ |
- |
+ |
+ |
4 |
CcRz6 |
+ |
+ |
+ |
+ |
5 |
CcRz7 |
+ |
- |
+ |
+ |
6 |
CcRz9 |
+ |
+ |
+ |
+ |
7 |
CcRz12 |
+ |
- |
+ |
+ |
8 |
CcRz17 |
+ |
- |
+ |
+ |
9 |
CcRz21 |
+ |
+ |
+ |
+ |
10 |
CcRz24 |
+ |
- |
+ |
+ |
11 |
PpRz1 |
+ |
+ |
- |
+ |
12 |
PpRz4 |
+ |
- |
+ |
+ |
13 |
CaL3 |
+ |
- |
+ |
+ |
14 |
CaL6 |
+ |
- |
+ |
+ |
15 |
CaS4 |
+ |
+ |
+ |
+ |
16 |
AoS1 |
+ |
+ |
+ |
+ |
17 |
AoS2 |
+ |
+ |
- |
+ |
18 |
VrL2 |
+ |
+ |
- |
+ |
19 |
VrS4 |
+ |
+ |
+ |
+ |
20 |
KrRz5 |
+ |
+ |
- |
+ |
Table 4 Screening for plant growth promoting (PGP) activities
Figure 5 N=57; Epidemiological distribution of the pathological fractures, traumatic fractures, and nonunion.

Figure 6 N=57; Epidemiological distribution of the pathological fractures, traumatic fractures, and nonunion.
Seven (7) strains (CcRz1, CcRz6, CcRz9, CcRz21, CaS4, AoS1 and VrS4) showed positive results in all the PGP traits tested. Five (5) bioactive strains (CcRz3, PpRz1, AoS2, VrS2 and KrRz5) were positive in IAA, siderophore and ammonia production tests but negative in phosphate solubilization. Eight (8) strains (CcRz4, CcRz7, CcRz12, CcRz17, CcRz24, PpRz4, CaL3 and CaL6) were positive in IAA, phosphate solubilization and ammonia production tests but negative in siderophore production.
Plants growing in great areas with rich biodiversity are likely to house endophytes with equal or greater biodiversity. Plants with an ethnobotanical history and unusual longevity are expected to be more potent sources of endophytes producing active natural products.20 In this study, we have isolated 104 putative endophytic actinomycetes from eight ethnomedicinally important plants of Manipur. Eighty-one (81) putative endophytic strains were selected for antimicrobial assays. Zhao et al.45 reported 560 endophytes from 26 species of healthy medicinal plants where more number of isolates were recovered from roots (58.2%), followed by stems (27.8%) and leaves (14%).45 Actinomycetes have been indicated as a large part of the endophytic microbial flora.46
As described in earlier studies, the strains we isolated possessed more antifungal than antibacterial properties.47,48 Primary screening revealed that 37 of 81 isolates have antibacterial activity against one or more of the test organisms of which 9 were potent. In Secondary screening, 11 isolates exhibited antimicrobial activity, of which 4 were found to be potent. None of the isolates were found to have any activity against Pseudomonas aeruginosa. Biocontrol assay against six rice fungal pathogens indicated that 21 isolates have antifungal activity against one or more of the test organisms, of which CcRz4 and CaR1 were found to be the most potent and they hold promise for further development as biocontrol agents. The results of this study indicate that these endophytic isolates from medicinal plants in Manipur have potential to be used as biological control agents against fungal phytopathogens. Preliminary characterization of these 37 bioactive actinomycete strains by biochemical and physiological tests gave results typical of actinomycetes.
There are many reports which demonstrated the ability of endophytic and rhizospheric soil Streptomyces to produce indole acetic acid and thus promote plant growth.50,51 Twenty-eight of our isolates produced IAA. Endophytic actinomycetes were reported to produce IAA ranging between 9.85-15.4 μg/ml.52 In agriculture, biological phosphate solubilization as an alternative to natural phosphate utilization plays an important role in efficient nutrient uptake. 20 endophytic isolates were positive for P solubilization and 27 for ammonia production. In addition, 14 isolates produced siderophore. Siderophore production may be involved in the inhibition of pathogens and, indirectly. in promotion of plant growth.53-55
Our study revealed that medicinal plants in Manipur are a promising source of endophytic bacteria with biocontrol and PGP potential. Further studies are underway to assess the agricultural applications of these endophytic strains.
Among 37 endophytic actinomycetes screened for antimicrobial activities, 4 (CcRz22, CaL6, CaR5, AoS2) strains were found to be promising. The strain CcRz4 and CaR1 were found to be most promising biocontrol strains. Seven strains (CcRz1, CcRz6, CcRz9, CcRz21, CaS4, AoS1 and VrS4) showed positive results in all the PGP traits tested. Optimization studies of these bioactive strains by changing cultural conditions could be targets of future studies leading to biotechnological exploitation of these bioactive strains. The study also corroborate that Manipur (a part of Indo-Burma hotspot) holds great potential for discovery of novel actinomycetes and development of novel natural products with commercial biotechnological applications.
The authors would like to gratefully acknowledge the Department of Biotechnology (DBT), Govt. of India, for grant towards the SBT Hub scheme, Department of Biochemistry, Manipur University (BT/04/NE/2009) that partly facilitated this work.
SK thanks the Department of Science & Technology (DST), Govt. of India for providing the INSPIRE Fellowship for PhD work (DST/ INSPIRE Fellowship/2014/195).
Khullakpam Shaheen conducted the experiments and wrote the initial draft of the manuscript. Debananda S. Ningthoujam designed and supervised the study and gave critical, analyses, reviews and comments. Saikat Mukherjee helped edit the initial versions of the manuscript.
The author declares no conflict of interest.

©2017 Shaheen, et al. This is an open access article distributed under the terms of the, which permits unrestricted use, distribution, and build upon your work non-commercially.